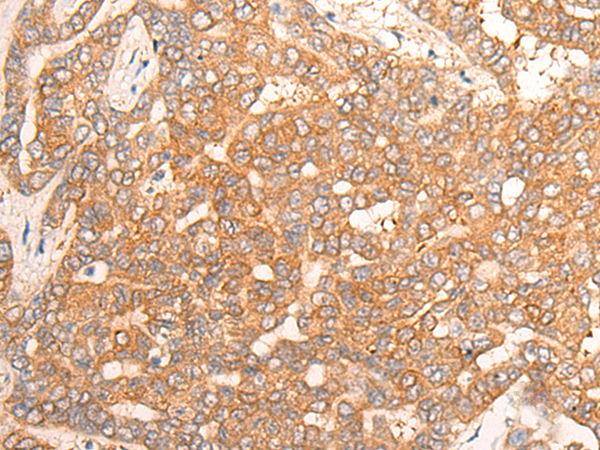
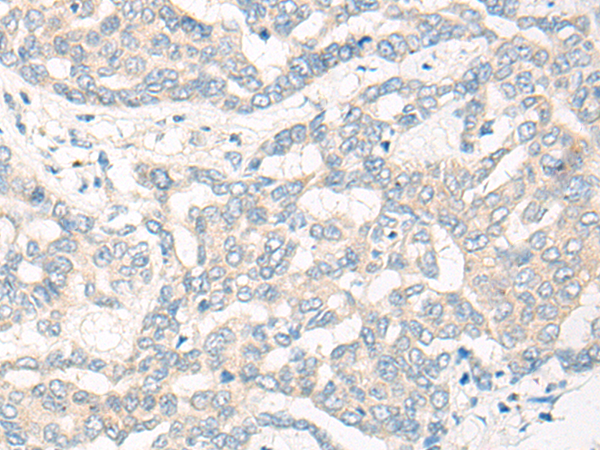

-
分类: 科研抗体货号: P13214别名: PHN; CPSASE1应用: IHC反应种属: Human, Mouse, Rat
-
分类: 科研抗体货号: P13203别名: UV20; COFS4; RAD10应用: WB反应种属: Human, Mouse
-
分类: 科研抗体货号: P13213别名: CP110; Cep110应用: IHC反应种属: Human, Mouse
-
分类: 科研抗体货号: P13202别名:应用: WB反应种属: Human, Mouse
-
分类: 科研抗体货号: P13212别名: CEMCOX2应用: IHC反应种属: Human
-
分类: 科研抗体货号: P13229别名: HG57; CYSLT2; GPCR21; HPN321; CYSLT2R; KPG_011; hGPCR21; PSEC0146应用: WB,IHC反应种属: Human, Mouse
-
分类: 科研抗体货号: P13211别名: EAR3; BBOAS; EAR-3; NR2F2; SVP44; BBSOAS; ERBAL3; TFCOUP1; COUP-TFI; TCFCOUP1应用: WB,IHC反应种属: Human, Mouse
-
分类: 科研抗体货号: P13227别名:应用: IHC反应种属: Human, Mouse
-
分类: 科研抗体货号: P13210别名: LCF; NIL16; PRIL16; prIL-16应用: IHC反应种属: Human
-
分类: 科研抗体货号: P13226别名: CPC8; CYPIIC8; MP-12/MP-20应用: IHC反应种属: Human

鄂公网安备42018502007531号
鄂公网安备42018502007531号

